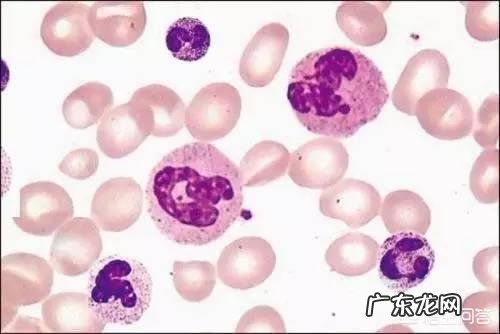
白细胞低的原因是什么？有什么危害？

当白细胞轻度对身体的免疫反应影响不大 。
白细胞重度降低,身体的抵抗力差,容易感染 。这也是骨髓移植患者面临的最严重和最棘手的问题 。
成人:(4~10)×10^9/L;
新生儿:(15~20)×10^9/L;
6个月~2岁:(11~12)×10^9/L 。

文章插图
(1)病毒感染是引起白细胞降低的最常见原因,比如感冒、水痘、风疹、病毒性肝炎等 。
(2)细菌感染多引起白细胞升高,但是某些细菌感染后反而降低,如伤寒、副伤寒 。
(3)某些寄生虫感染:疟疾、黑热病 。
(4)各种原因引起的脾大、脾功能亢进:肝硬化、肝癌、淋巴瘤等 。
(5)血液系统疾病:再障、巨幼细胞贫血、严重缺铁性贫血、阵发性睡眠性血红蛋白尿、非白性白血病、骨转移癌等 。
(6)多种放射线损害,如X线、γ射线、放射性核素 。
(7)药物引起:抗肿瘤药、抗糖尿病药、抗甲状腺药、干扰素、磺胺类和氯霉素等抗生素 。
(8)化学物质损伤:苯、铅、贡等 。
(9)系统性红斑狼疮,自身抗体引起的白细胞减少 。

文章插图

文章插图
一、什么是白细胞?
医学上,所谓白细胞(WBC),是血液中,一类常规细胞 。一般包括:中性粒细胞、嗜酸性粒细胞、嗜碱性粒细胞、单核细胞、淋巴细胞等 。
白细胞------具有吞噬细菌、防御疾病等作用 。简单地说,就像是国家军队,保家卫国作用 。
正常成人,血液中,白细胞数目,大概(4.0~10.0)×10^ 9/L 。其中,中性粒细胞占50%~70%;嗜酸性粒细胞占0.5%~5%;嗜碱性粒细胞占0~1%;单核细胞占3%~8%;淋巴细胞占20%~40% 。
二、白细胞降低,有哪些原因?
1、最常见的,就是血液系统疾病 。像白血病、再生障碍性贫血等等 。
2、药物性白细胞减少 。像抗痨药物、抗甲亢药物等等 。特别是癌症化疗 。
3、理化因素 。
血常规化验是我们最常接触到的检验项目之一,可以为很多疾病提供诊断支持,其中有一项就是白细胞,白细胞=白血球,它是血液独有的免疫细胞,是与疾病斗争的“卫士” 。

文章插图
血液系统疾病会引起白细胞减少,包括再生障碍性贫血、白血病、骨髓增生异常综合症等;
药物可导致白细胞减少,比如:抗肿瘤放化疗药物,解热镇痛类药物、抗菌药物、免疫抑制剂、抗甲状腺药物等等;
病毒感染引发的白细胞减少,暂时破坏了骨髓的正常功能;如流行性感冒、病毒性感染等炎症疾病出现后,同样会导致体内白细胞减少 。
免疫系统出现了问题,白细胞有提高人体免疫力的作用,但是当人体患上免疫系统疾病后,容易引发白细胞的减少,如类风湿性关节炎就是其中的一种 。
文章插图
由于白细胞的数量下降,机体的抵抗力就会下降,会出现乏力、头晕、低热、食欲减低、心慌等症状 。由于抵抗力下降,就会给细菌,病毒和真菌等微生物可乘之机 。所以,白细胞降低的人通常会容易合并感染,会经常性的感冒,发烧,肌肉酸痛 。而且白细胞减少的患者,容易出现严重的感染,一个小小的感冒可能发展为致病的感染,例如重症肺炎,感染中毒性休克等等 。
哪些人群要小心白细胞的减少呢?
- 红线图是怎么来的
- 适合放客厅的大盆绿植
- 关于植树节的名人名言 有关植树节名言
- 平凡而不平庸 平庸与快乐
- 春运最繁忙的线路 春运路线规划
- 别墅庭院最适合种什么样的草
- 家里的开关经常跳闸是什么原因?
- 婺源铺床习俗
- 好的服务必定是超前的(64):危险防范通知触达示例(上)
- 有哪些一个人心累想哭的说说句子?
特别声明:本站内容均来自网友提供或互联网,仅供参考,请勿用于商业和其他非法用途。如果侵犯了您的权益请与我们联系,我们将在24小时内删除。
